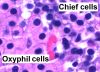

Most viewed |

Rectum - histology slide64 views
|
|

Prostate, rodent (labels) - histology slide64 views
|
|

Pituitary gland - pars distalis - histology slide60 views
|
|

Urethra, female - histology slide55 views
|
|

Fibroblasts, mouse embryo5 views
|
|

Polarized light - histology slide2 views
|
|
Parathyroid gland (labels) - histology slide1 views
|
|

Parathyroid gland - histology slide1 views
|
|

Spinal cord, rat - immunoflorescence histology slide1 views
|
|

Immunoflorescence1 views
|
|

Thyroid gland - histology slide1 views
|
|

Cardiac muscle - histology slide1 views
|
|
4044 files on 337 page(s) |
 |
 |
 |
 |
 |
 |
 |
 |
 |
337 |
|